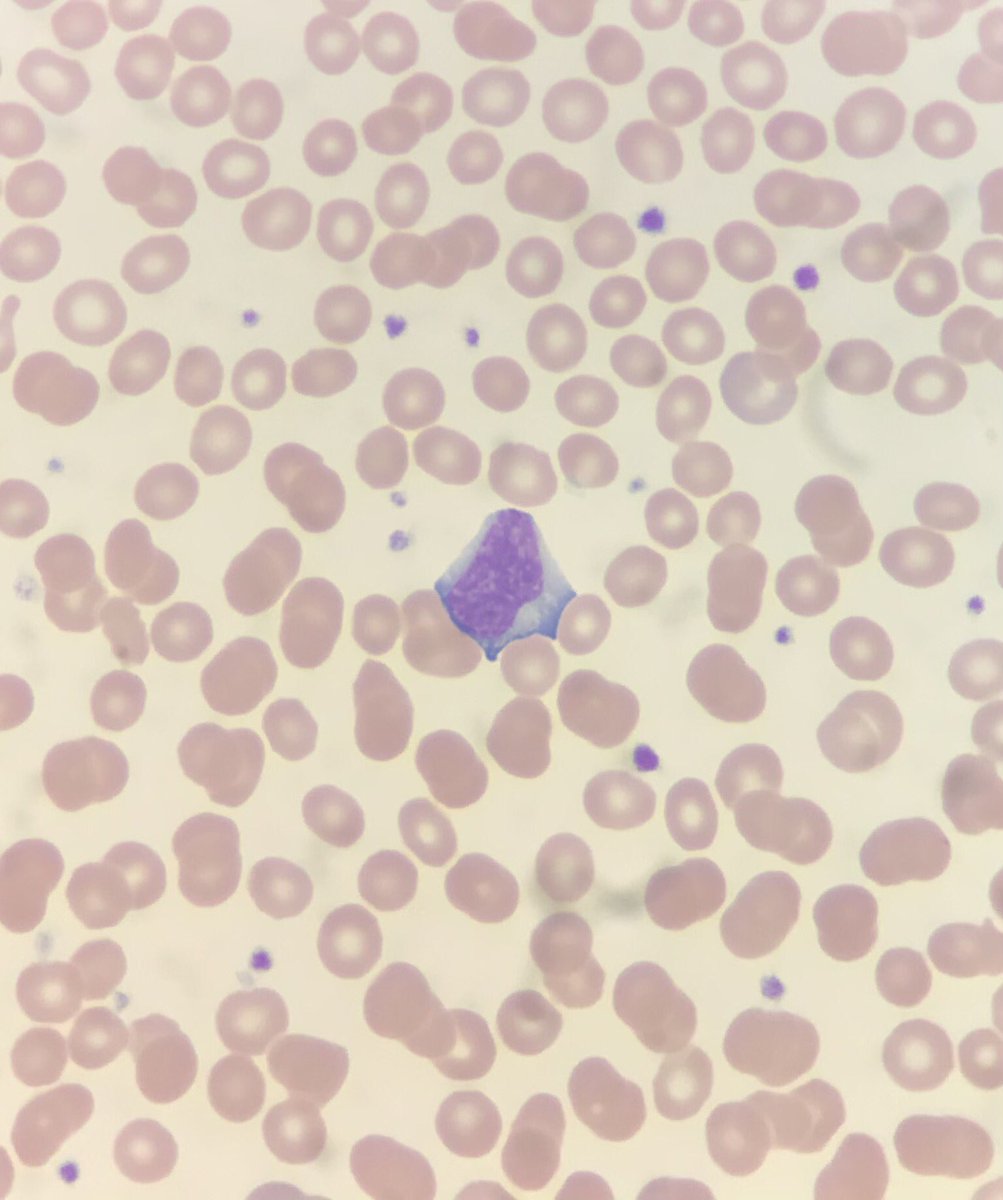
Numerous lymphocytes like this one on a smear review of a teenager presenting with pharyngitis and low grade fever. Can anyone guess results of the Monospot test? #blooducation

Maryam Sayah, MD
@pathologysayah
#Hematopathology Fellow @UCLA. Views are my own
ID: 782159745314467840
01-10-2016 10:06:30
9,9K Tweet
4,4K Followers
3,3K Following

Checkout the #PathTweetAward moment for October 5 - October 11 2020! Sanjay Mukhopadhyay Celina Stayerman MD Vidya Monappa E. Heidi Cheek, MHS, PA(ASCP) Vijay Shankar S @SwikrityUMD @vhnguyenmd Luis Humberto Cruz C Daliah A/Hafeez, MD Laura G. Pastrián MD Daniela Hermelin, MD Nigar Anjuman Khurram Olaleke Folaranmi Maryam Sayah, MD x.com/i/events/13175…

My ABPath practice tutorial did not go smoothly at all... if you haven't taken it yet, make sure you do the following BEFORE the practice tutorial: (1) uninstall Skype (2) turn off Windows firewall (3) uninstall/disable any antivirus software #pathboards American Board of Pathology






Check out these beautiful cells from a bone marrow aspirate smear! What are they? 📸by Alessa Aragao, MD











This cell is usually difficult to see because it is hidden within bone marrow spicules. But once in a while, it is out in the open. What is this cell? 📸by Alessa Aragao, MD


Happy international pathology day Patoloji Dern Fed kemal bakir @pathos_risus Güliz Akdaş Barkan Alp Usubutun ERDENER OZER gulcin guler simsek, MD şirin küçük Duygu Sener Hatice Olger Uzuner,MD Eylül Gün, MD FRCPath Şeyma Büyücek micheal ali engin slowcytology @iremessa Şeyma Yalçın, MD Reyhan Egilmez B. Gizem Özamrak, MD Özkan Aydın, MD